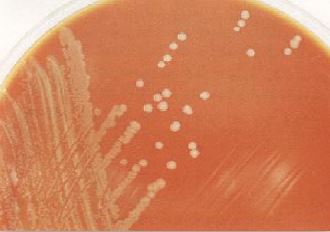
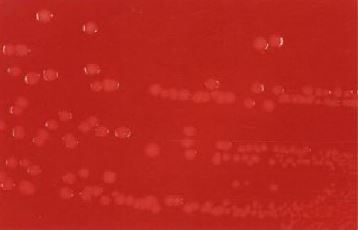

النبات

مواضيع عامة في علم النبات

الجذور - السيقان - الأوراق

النباتات الوعائية واللاوعائية

البذور (مغطاة البذور - عاريات البذور)

الطحالب

النباتات الطبية


الحيوان

مواضيع عامة في علم الحيوان

علم التشريح

التنوع الإحيائي

البايلوجيا الخلوية


الأحياء المجهرية

البكتيريا

الفطريات

الطفيليات

الفايروسات


علم الأمراض

الاورام

الامراض الوراثية

الامراض المناعية

الامراض المدارية

اضطرابات الدورة الدموية

مواضيع عامة في علم الامراض

الحشرات


التقانة الإحيائية

مواضيع عامة في التقانة الإحيائية


التقنية الحيوية المكروبية

التقنية الحيوية والميكروبات

الفعاليات الحيوية

وراثة الاحياء المجهرية

تصنيف الاحياء المجهرية

الاحياء المجهرية في الطبيعة

أيض الاجهاد

التقنية الحيوية والبيئة

التقنية الحيوية والطب

التقنية الحيوية والزراعة

التقنية الحيوية والصناعة

التقنية الحيوية والطاقة

البحار والطحالب الصغيرة

عزل البروتين

هندسة الجينات


التقنية الحياتية النانوية

مفاهيم التقنية الحيوية النانوية

التراكيب النانوية والمجاهر المستخدمة في رؤيتها

تصنيع وتخليق المواد النانوية

تطبيقات التقنية النانوية والحيوية النانوية

الرقائق والمتحسسات الحيوية

المصفوفات المجهرية وحاسوب الدنا

اللقاحات

البيئة والتلوث


علم الأجنة

اعضاء التكاثر وتشكل الاعراس

الاخصاب

التشطر

العصيبة وتشكل الجسيدات

تشكل اللواحق الجنينية

تكون المعيدة وظهور الطبقات الجنينية

مقدمة لعلم الاجنة


الأحياء الجزيئي

مواضيع عامة في الاحياء الجزيئي


علم وظائف الأعضاء


الغدد

مواضيع عامة في الغدد

الغدد الصم و هرموناتها

الجسم تحت السريري

الغدة النخامية

الغدة الكظرية

الغدة التناسلية

الغدة الدرقية والجار الدرقية

الغدة البنكرياسية

الغدة الصنوبرية

مواضيع عامة في علم وظائف الاعضاء

الخلية الحيوانية

الجهاز العصبي

أعضاء الحس

الجهاز العضلي

السوائل الجسمية

الجهاز الدوري والليمف

الجهاز التنفسي

الجهاز الهضمي

الجهاز البولي


المضادات الميكروبية

مواضيع عامة في المضادات الميكروبية

مضادات البكتيريا

مضادات الفطريات

مضادات الطفيليات

مضادات الفايروسات

علم الخلية

الوراثة

الأحياء العامة

المناعة

التحليلات المرضية

الكيمياء الحيوية

مواضيع متنوعة أخرى

الانزيمات
الجنس Neisseria meningitidis
المؤلف:
عبد الرزاق سليمان التومي ، محمد محمد الامام ، عبد الباسط رمضان
المصدر:
اساسيات التشخيص البكتريولوجي المعملي والسريري
الجزء والصفحة:
20-7-2016
3837
Neisseria meningitidis
هذا النوع البكتيري سالب لصبغة جرام خلاياه ثنائيات diplocooci تشبه حبوب البن coffee bean sahped وتتواجد في الغالب في مجاميع ، كما أنها غالباً ما تكون متعددة الأشكال وقطرها حوالي 1 ميكرومتر وهي غير متحركة وتحتوي على حافظة ولتنميتها على المزرعة البكتيرية لابد من توفر الدم وتركيز 10-5% من ثاني أكسيد الكربون. في اللطاخة يلاحظ تواجد الخلايا البكتيرية داخل intracellular الخلايا الصديدية pus cells وبعد الخلايا البكتيرية قد تتوجد خارج extracellular خاصة إذا ما تضررت الخلايا الصديدية خلال عمل اللطاخة . ولتجنب تضرر الخلايا الصديدية يتم بتلامس الماسحة القطنية برفق مع الشريحة كما يتم تثبيت اللطاخة باستعمال الكحول الميثانولي methanol بدلاً من التثبيت بالتسخين.

صبغة جرام للنوع البكتيري N. Meningitidesمن عينة راسب سائل النخاع الشوكي
يعتمد تصنيف هذا النوع البكتيري على مستضد الحافظة عديدة السكريات حيث تم تصنيفها إلى 13 مجموع مصلية وتعتبر الأنواع المصلية A و B و C و Y و X وكذلك w135. تعتبر المجموعة المصلية A والمجموعة المصلية B ويتواجد النوع البكتيري N. meningitides كفلورا طبيعية للبلعوم الحلقي في أكثر من 25% من الأشخاص الأصحاء.
الامراضية :
يسبب النوع البكتيري N. meningitides إلتهاب السحايا الصديد poyogenic meningitis والذي غالباً ما يلي الإصابة بتعفن الدم bacteraemia والذي تظهر فيه الأعراض بصورة مفاجئة خلال 3-2 أيام من إنقضاء فترة الحضانة وتكون على هيئة صداع شديد مع قيء وتصلب الرقبة meck stiffness.
يعتبر هذا النوع البكتيري المسبب الرئيسي لأغلب الجائحات الوبائية والمتوطنة حوالي 12 حالة إصابة لكل 100000 شخص في السنة أما في دول العالم النامي خاصة في دول ما وراء الصحراء الإفريقية والتي تعرف بحزام إلتهاب السحايا meningitis belt والتي تبدأ من دول السنغال وغامبيا وكذلك غينياً بيساو وإثيوبيا وموزمبيق وأنغولا وناميبيا فإن معدل الإصابات أعلى من ذلك بكثير وغالباً ما تحدث هذه الأوبئة في فصول السنة الباردة من جراء الرذاذ الملوث مما يؤدي لتزايد عدد الوفيات خاصة بين الأطفال . 90% من الجائحات تحدث نتيجة الإصابة بالمجموعة المصلية A ، كما يمكن للمجموعة المصلية C أحداث الإصابات في دول الإصابات في دول أفريقيا أما المجموعة B فهي المسئولة على إحداث الإصابة في كوبا وجنوب امريكا كما سجل وجودها في أفريقيا وبعض دول العالم الاخرى. اما المجموعة المصلية W135 فهي المسئولة على إحداث الجائحات في بوركينا فاسو وبين الحجيج في السعودية ، معدل الوفيات قد يصل إلى 85% من إجمالي الحالات إن لم يتم علاجها وقد تنخفض هذه النسبة لتصل إلى أقل من 1% في حال الإسراع في العلاج. كما ينصح بإعطاء المضاد الحيوي المناسب كعلاج وقائي للأشخاص المرافقين للمريض (أفراد الأسرة زملاء المدرسة ، ...) ويتم علاج الحال بإعطاء المضاد الحيوي penicillin ويمكن إعطاء المضاد الحيوي minocylin أو المضاد الحيوي rifampicin كعلاج بديل ويعتمد البرنامج التطعيمي vaccination باستعمال عديد سكريات الحافظة النقيء للمجموعة المصلية A والمجموعة Y وكذلك المجموعة المصلية W135 أما المجموعة المصلية B فلا يوجد لها تحصين وقاني لها حيث إن الحافظة مكونة من Polyneuraminic acid والتي لا يمكن للجهاز التعرف عليه كجسم غريب.
كما يسبب هذا النوع البكتيري تجرثم الدم septicaemia والذي غالباً ما يكون حاد ومميت ومصحوب بحمى، كما يتصف بوهن شديد وطفح مدمي haemorrhagic rash ووجود بثرات petechiae على ملتحمة العين.
ويعتبر التهاب المفاصل المزمن من الإصابات النادر إحداثها من قبل هذا النوع البكتيري.

Meningoccemia
التشخيص المعملي :
هذا النوع البكتيري هوائي وينمو جيداً في المزرعة البكتيرية في بيئة مشبعة بغاز ثاني أكسيد الكربون ، ويفضل النمو في درجات حرارة ما بين 42-25 درجة مئوية إلا أن درجة حرارة 373-35 درجة مئوية تعتبر الحرارة المثلى للنمو ويفضل استعمال أوساط غذائية مغذية enriched media، ومن المهم جداً زرع العينات على الوسط الغذائي المناسب بأسرع ما يمكن بعد تجميعها.
بعض البحاث ينصح بتنمية عينة CSF على الوسط الغذائي Robertson's cooked meat medium والوسط الغذائي chocolate.
ــ الوسط الغذائي chocolate agar : تظهر المستعمرات النامية شفافة اللون أو رمادية لماعة، حجمها 2-1 مم وذلك بعد تحصينها في وجود غاز ثاني أكسيد الكربون. المجموعة المصلية A والمجموعة C تظهر مستعمرات بكتيرية أكبر حجماً وأكثر لزوجة mucoid من مستعمرات المجموعة B حيث تظهر مستعمرات هذه المجموعة بلون رمادي مصفر grey-yellow.
مستعمرات النوع البكتيري N. meningitidesعلى الوسط الغذائي chocolate agar
ــ الوسط الغذائي Mueller Hintor agar : يمكن لهذا النوع البكتيري النمو في هذا الوسط الغذائي بدون الحاجة لإضافة دم.
ــ الوسط الغذائي blood agar : ينمو هذا النوع البكتيري النمو بصورة جيدة في الوسط الغذائي Columbia diphasic medium وحيث أن مادة sodium polyanethol sulphonate (SPS) الذي قد يكون مثبط لنمو هذا النوع البكتيري فإن بعض البحاث ينصح بإضافة الجيلاتين المعقم بتركيز 1% لمعادة تأثير SPS المثبط.
يتم إعادة تنمية المستعمرات النامية على الوسط الغذائي blood agar من جديد على الوسط الغذائي chocolate وتحضينه في بيئة تحتوي على ثاني أكسيد الكربون.
مستعمرات النوع البكتيري N. meningitides على الوسط الغذائي blood agar
الاختبارات المعملية :
من العينات التي يمكن تجميعها سائل النخاع الشوكي وعينة الدم وذلك بإجراء المزرعة البكتيرية كما يمكن أخذ مسحة الجلد المدمية haemorrhagic skin lesions.
ــ اختبار الكشف على إنزيم oxidase : موجب. وهو يعتبر اختبار افتراضي للتعرف على هذا النوع البكتيري في حالات التهاب السحايا وذلك من عينة سائل النخاع الشوكي وبالتالي يجب إجراء الاختبارات المصلية.
ــ اختبار الكشف على تخمير سكر الجلوكوز وسكر المالتوز : موجب.
ــ اختبار الكشف على تخمير سكر السكروز وسكر اللاكتوز : سالب.
ــ اختبار الكشف على إنزيم DNase : سالب.
ــ اختبار الكشف على إنزيم beta – galactosidase (ONPG) : سالب.
ــ اختبار الكشف على إنزيم glutamylaminpeptidase (GAP) : موجب .
الاختبارات المصلية :
يمكن لمستضيد الحافظة عديدة السكريات لهذا النوع البكتيري تواجده في عينة سائل النخاع الشوكي أو في عينة البول في عينة المصل وهناك العديد من الاختباراتا لتي يمكن إجرائها مثل اختبار التلازن المباشر direct latex agglutination tesr أو اختبار coagulation slide antigen tests وهذه الاختبارات تلعب دوراً هاماً عند عدم إمكانية اجراء الاختبارات المعملية .

موضع أخذ عينة سائل النخاع الشوكي

كيفية أخذ عينة سائل النخاع الشوكي
 الاكثر قراءة في البكتيريا
الاكثر قراءة في البكتيريا
 اخر الاخبار
اخر الاخبار
اخبار العتبة العباسية المقدسة

الآخبار الصحية















 قسم الشؤون الفكرية يصدر كتاباً يوثق تاريخ السدانة في العتبة العباسية المقدسة
قسم الشؤون الفكرية يصدر كتاباً يوثق تاريخ السدانة في العتبة العباسية المقدسة "المهمة".. إصدار قصصي يوثّق القصص الفائزة في مسابقة فتوى الدفاع المقدسة للقصة القصيرة
"المهمة".. إصدار قصصي يوثّق القصص الفائزة في مسابقة فتوى الدفاع المقدسة للقصة القصيرة (نوافذ).. إصدار أدبي يوثق القصص الفائزة في مسابقة الإمام العسكري (عليه السلام)
(نوافذ).. إصدار أدبي يوثق القصص الفائزة في مسابقة الإمام العسكري (عليه السلام)


















